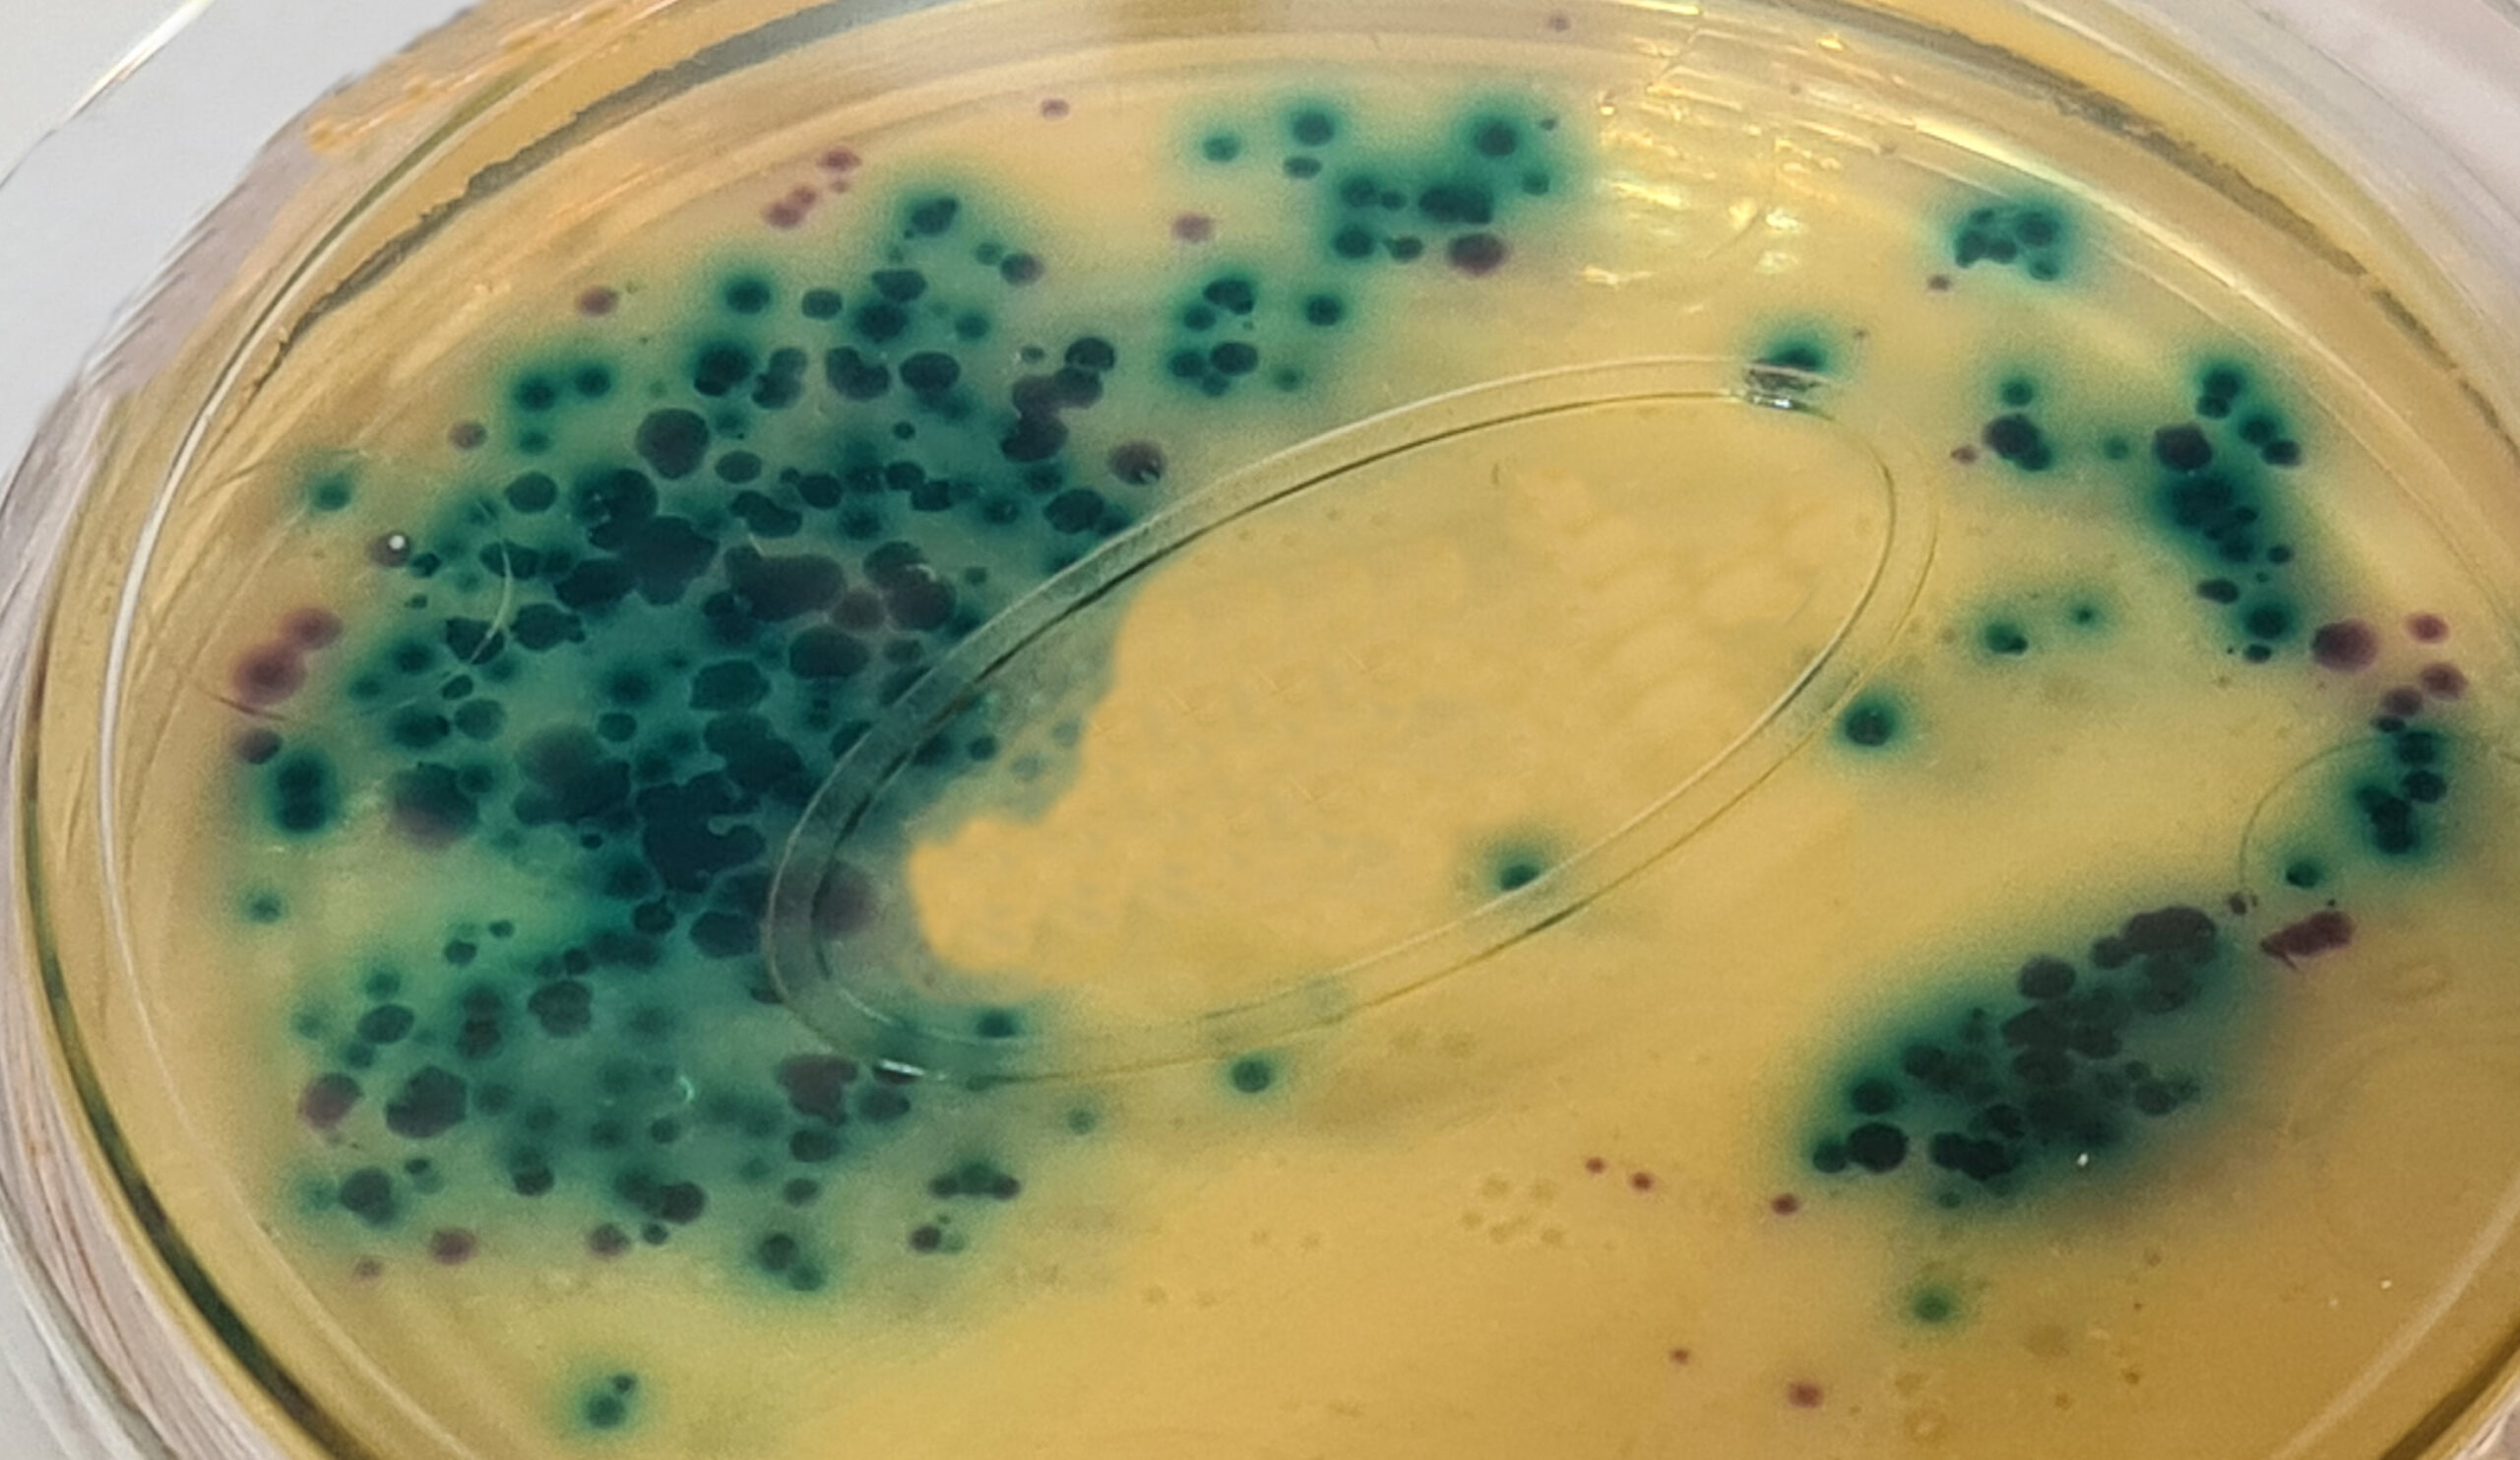

ISO 15213-1:2023 para recuento de Clostridium sulfito-reductores en alimentos, con el medio ISA (Sulfite Iron Agar) y 2 soluciones especiales (una para la solución madre y otra para las diluciones)
En MICROKIT disponemos ya de los 4 medios que necesita para el recuento de Clostridios Sulfito-Reductores siguiendo esta nueva Norma ISO 15213-1 de 2023:
1-El Sulfite Iron Agar (ISA) sufre una modificación en su fórmula, que ya hemos corregido para adaptarnos a esta nueva Norma ISO
2-La solución madre se hace en un caldo especial, que ya tenemos disponible en botes de 500 g para autoclavar
3-Las diluciones se realizan en otro caldo diferente, que también ofrecemos en botes de 500 g para autoclavar
4-Las confirmaciones se hacen en agar sangre Columbia, con el cual contamos (medio base) desde hace 33 años
Solicite precios y plazos de entrega (en principio inmediatos) de todos estos medios, en microkit@microkit.es
Adjuntamos fotografias de los folletos de los 3 primeros medios, con fórmulas idénticas a las indicadas en esta Norma ISO 15213. Del Agar sangre Columbia no adjuntamos, porque no ha sufrido modificación alguna.
En este medio modificado de su original Wilson-Blair, si sólo se buscan esporas, calentar la muestra y su serie de diluciones decimales en baño María 10-15 minutos a unos 70-80 ºC.
Para aguas, filtrar 100 ml de muestra a través de 0,22 µm (VAC022) y depositar la membrana invertida en la placa Petri vacía.
En alimentos, sembrar 1 ml de muestra y de sus diluciones en sendas placas Petri vacías.
Añadir de inmediato en cada placa Petri 12-15 ml del medio enfriado a unos 50 ºC, sin que se formen burbujas.
Una vez solidificado, añadir otros 5 mL para evitar el desarrollo de colonias invasivas.
Para siembra directa sin filtración de aguas cloradas, añadir 0,6 g de Tiosulfato sódico para inactivar el cloro.
Incubar 48±2 horas a 37±1 ºC, en atmósfera de anaerobiosis (ej: KKT001 en bolsa para < 7 placas de 90 mm, < 20-25 plaquitas MF, KKM036 para jarras) controlada (KKM039).
Contar las colonias (no nubes de productores de hidrógeno) negras, grises o marrones, típicas de productores de SH2.
Realizar los recuentos nada más sacar de la atmósfera de anaerobiosis, ya que la reacción de color revierte en presencia de aire.
Confirmar 5 colonias típicas, estriando en 2 placas de agar sangre con base Columbia (DMT020), incubar una de ellas en aerobiosis y la otra en anaerobiosis, a 37ºC durante 20h.
Las colonias confirmativas de Clostridios sulfito reductores habrán crecido en estría en la placa en anaerobiosis, pero no en la incubada en aerobiosis.
La Norma exige el empleo de estos diluyentes de la muestra: Usar los medios DMT277 y DMT278 para realizar la solución madre y las diluciones decimales, respectivamente, eliminando así inhibidores que pueda haber en la muestra.
https://www.microkit.es/microbiologia-de-alimentos.htm





¿HA OÍDO HABLAR DEL EFECTO MATRIZ?